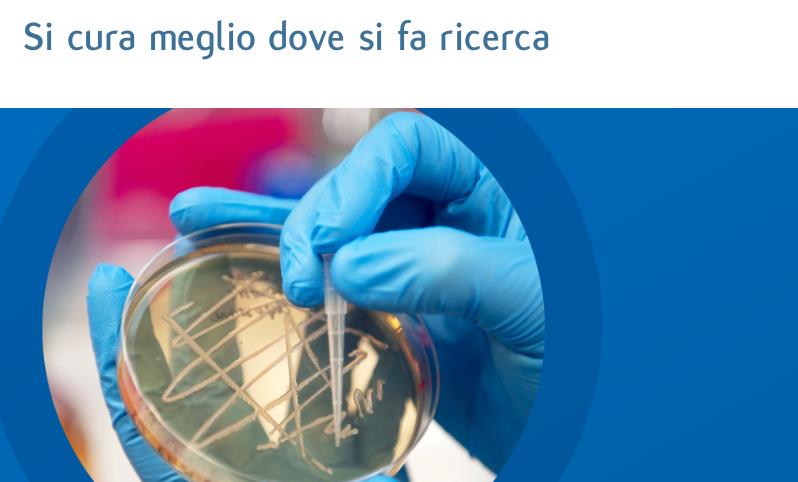

APPELLO PER LA RICERCA SCIENTIFICA E LA SCIENZA: tuteliamo il sistema sanitario nazionale ma anche la ricerca scientifica e la scienza!
Se prima quei signori chiusi in quelle piccole stanzette o loculi che sono i laboratori di ricerca nelle nostre università ma anche scienziati che indipendentemente e privatamente ogni giorno svolgono attività di ricerca facendo pubblicazioni, divulgando le loro scoperte o anche semplicemente la loro conoscenza non facessero questo lavoro non si scoprirebbero le cause di molte malattie e non si saprebbe neanche come è fatta una cellula.
E nonostante questo la ricerca italiana non è ancora al centro delle priorità del paese, un giornalista e una volta disse la ricerca non è di moda! Perché non si capisce che se non si riparte da essa questo paese non ha futuro, con ricercatori e i ragazzi che vanno all’estero o fanno lavori che non sono il frutto del loro percorso di studi perché qui in Italia gli si dice che il curriculum è troppo lungo o che sono troppo specializzati con aziende che non assumono personale che può dare quel l’input in più all’azienda e poi alla ricerca nazionale e globale o scoperte che restano recluse nei laboratori e nella mente di chi l’ha create e che non vengono poi impiegate nel terzo settore e nell’industria non potendo quindi sviluppare il suo potenziale.
Questo è il mio miserabile appello che faccio al paese che riscopra l’amore per la ricerca scientifica e per la scienza e che dia veramente la possibilità a noi giovani di dimostrare quello che valiamo.
Professione Erbochimico / Naturopata per Animali
Consulenza e Ricerca Controllo Qualità e Valutazione Farmacognostica e Citotossicologica degli Estratti Vegetali di Piante Officinali, Microalghe e Gemmoderivati e Ricerche Microbiota Piante Officinali
Responsabile Scientifico: Centro di Controllo e Divulgazione Scientifica sulle Sostanze Naturali – CCDsSN
Roma – Italia
E-mail: paolo.pelini@gmail.com
http://www.paolopelinierbochimico.it
CV: https://dmhomes.academia.edu/PaoloPelini/CurriculumVitae